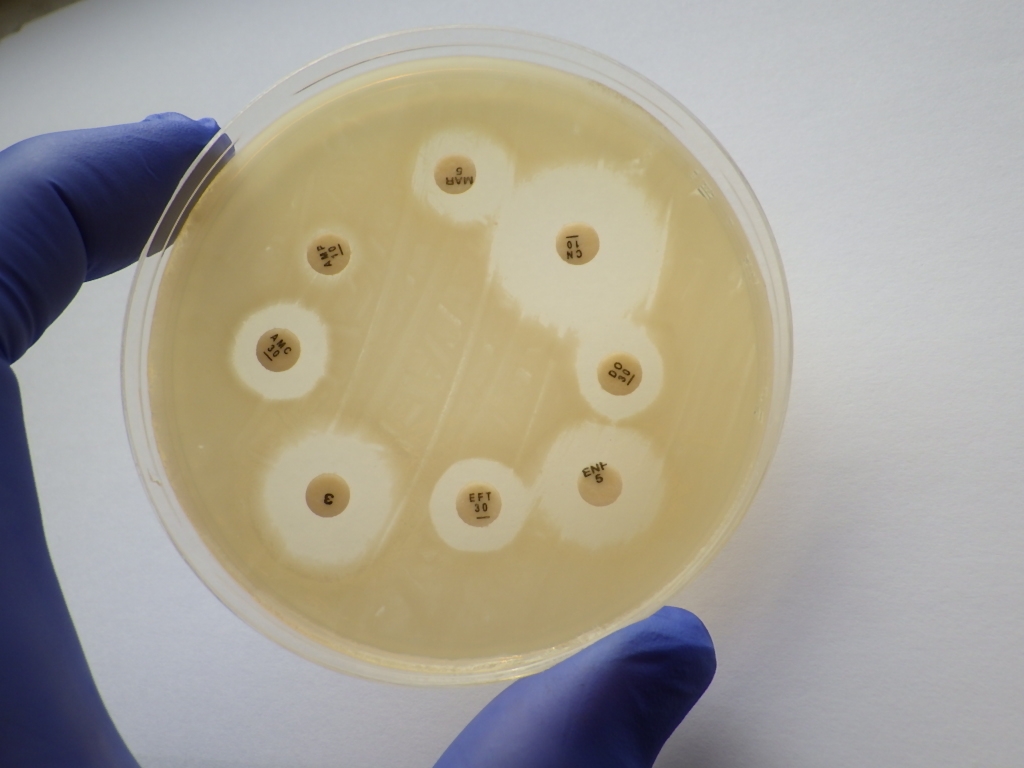
Please credit Rossdales Labs.  Caption:  Antimicrobial sensitivity testing using the disc diffusion technique.

Please credit Rossdales Labs. Caption: Antimicrobial sensitivity testing using the disc diffusion technique.
BEVA Supports European Antibiotic Awareness Day With Free Webinars
The British Equine Veterinary Association (BEVA) is showing its support for European Antibiotic Awareness Day on 18th November 2017 by giving all equine vets free online access to its outstanding antimicrobial Congress session at www.ebeva.org/congress17-session12
BEVA is a consistent campaigner for the responsible use of antibiotics; Last year it introduced the BEVA Antibiotic Champion Award to encourage members to document their efforts to reduce the use of critically important antibiotics. In 2015 the Association received a national Antibiotic Guardian award from Public Health England and was the only organisation from the veterinary profession to be shortlisted. In 2012 BEVA launched the Protect ME antimicrobial campaign to facilitate compliance and educate the public about the importance of antimicrobial awareness.
This year in recognition of European Antibiotic Awareness day (18th November) and also World Antibiotic Awareness Week (13th to 19th November, 2017) the free webinar, sponsored by HBLB, gives horse vets access to two informative lectures from the 2017 BEVA Congress: Antimicrobial resistance – One Health gets serious presented by Professor the Lord Trees and Antimicrobial use in equine practice presented by John Marshall.
Professor Josh Slater Chair of BEVA’s Health & Medicines Committee said: “EAAD is an excellent time for the profession to reflect on its successes in improving antibiotic prescribing and also an opportunity to plan for future improvements in antimicrobial stewardship.
“BEVA’s antibiotic champion award is a chance to recognise the massive contribution that equine vets have made in changing prescribing behaviours, in particular relating to critically important, or ‘protected’, antibiotics. The BEVA ProtectMe toolkit is freely available and has been proven to be an effective tool in support of this, but we are aware that practices may also have developed their own initiatives and hope to showcase these as part of the award scheme.”
The free webinars can be accessed at www.ebeva.org/congress17-session12
· To apply for BEVA Antibiotic Champion Award status visit http://www.beva.org.uk/Antibiotic-Champion-Award
· The BEVA Protect ME toolkit is free to BEVA members and can be downloaded at www.beva.org.uk.
· Members are also encouraged to sign up to be antibiotic guardians at www.antibioticguardian.com
More from BEVA
- Leading lights to present plenary lectures at BEVA Congress
- BEVA Congress applauds VNs with dedicated nursing stream
- Rising stars celebrated with BEVA One To Watch Award
- BEVA Reopens Popular Free Coaching Programme
- BEVA Congress 2026 to challenge how equine vets diagnose, treat and make decisions in practice

 9 years ago
9 years ago  1799 views
1799 views

 2 days ago
2 days ago